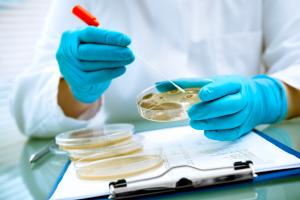
Akkermansia muciniphila, un bactérie qui vit dans le côlon, se révèle associée à une bonne santé (Visuel Adobe Stock 77074234)

Vous recherchez une actualité ou un dossier
Recherche (liste)
Mode d'affichage :
-
MICROBIOTE INTESTINAL : Un régulateur clé entre croissance tumorale et immunité
Actualité publiée le 14/04/2026AXE INTESTIN-CERVEAU : Utiliser le microbiote pour traiter Parkinson
Actualité publiée le 08/04/2026
-
CHIMIOTHÉRAPIE : Elle configure le microbiote de manière à freiner les métastases
Actualité publiée le 03/04/2026NEURODÉGÉNÉRESCENCE : Sur le nouvel axe clé intestin-cerveau-immunité
Actualité publiée le 10/03/2026
-
TROUBLES du SOMMEIL : Cibler l’axe intestin-cerveau
Actualité publiée le 09/01/2026CANCER et MICROBIOME : Un lien systématique ?
Actualité publiée le 07/01/2026
-
GASTRITE AUTO-IMMUNE : Le rôle clé du microbiote dans le risque de tumeurs endocrines
Actualité publiée le 08/12/2025SANTÉ DIGESTIVE : La nouvelle « capsule intelligente » qui analyse le tube
Actualité publiée le 26/11/2025
-
ÉPIGÉNÉTIQUE : Le rôle clé du microbiote dans l’expression des gènes
Actualité publiée le 26/11/2025MICROBIOTE INTESTINAL : Ces peptides alpha-défensines qui protègent contre l’obésité
Actualité publiée le 04/11/2025
-
DÉPRESSION : Le régime cétogène, un bon complément thérapeutique ?
Actualité publiée le 02/11/2025DIABÈTE : La berbérine contre ses effets neurologiques
Actualité publiée le 02/11/2025
-
HYPOTHYROÏDIE : Les bénéfices collatéraux des hormones pour le microbiote
Actualité publiée le 16/10/2025INSUFFISANCE CARDIAQUE : Le microbiote « compte » aussi
Actualité publiée le 04/10/2025
-
SCLÉROSE en PLAQUES : Le microbiote en question dans son déclenchement ?
Actualité publiée le 27/08/2025MICROBIOTE et CANCERS GASTRO-INTESTINAUX : Ces bactéries au rôle critique
Actualité publiée le 14/08/2025
-
PESTICIDES : Ils déciment aussi les bactéries du microbiote
Actualité publiée le 11/08/2025CANCER : Le traitement est aussi « alimentaire »
Actualité publiée le 06/08/2025
-
DÉPRESSION : La détecter par simple prélèvement de salive
Actualité publiée le 21/07/2025Transplantation de MICROBIOTE FÉCAL : Promesses ou risque possible pour la santé ?
Actualité publiée le 13/07/2025
-
IMMUNOTHÉRAPIE : La bactérie du microbiote qui booste la réponse immunitaire
Actualité publiée le 29/06/2025MICROBIOTE INTESTINAL : Il digère mais biotransforme aussi les médicaments
Actualité publiée le 29/05/2025
-
APNÉE du sommeil : La santé intestinale en cause ?
Actualité publiée le 21/05/2025L’ALIMENTATION est aussi et si thérapeutique
Actualité publiée le 11/05/2025
-
MICROBIOTE INTESTINAL : Ces acides biliaires naturellement anticancéreux
Actualité publiée le 18/04/2025ANTIBIOTIQUES chez l’enfant : Sur le risque accru d’asthme et d’autres allergies
Actualité publiée le 18/04/2025
-
MICROBIOTE INTESTINAL : Ces bonnes bactéries qui aiment le sucre
Actualité publiée le 04/03/2025RÉGIME, microbiote et graisses : Le trio qui détermine le cholestérol
Actualité publiée le 15/02/2025
-
MICROBIOME VAGINAL : Un rôle bien au-delà de l’hygiène intime
Actualité publiée le 10/02/2025RÉGIME MÉDITERRANÉEN : Bon pour le microbiote comme pour l’intellect
Actualité publiée le 08/02/2025
-
RÉGIME de JUS : En 3 jours seulement il nuit à la santé
Actualité publiée le 06/02/2025ALIMENTATION : Comment intégrer la viande dans un régime équilibré
Actualité publiée le 29/01/2025
-
FIBRES ALIMENTAIRES : Elles régulent aussi le fonctionnement de nos gènes
Actualité publiée le 12/01/2025MICROBIOTE : Exploiter la grande ingéniosité des bactéries pour la santé
Actualité publiée le 02/01/2025
Pages